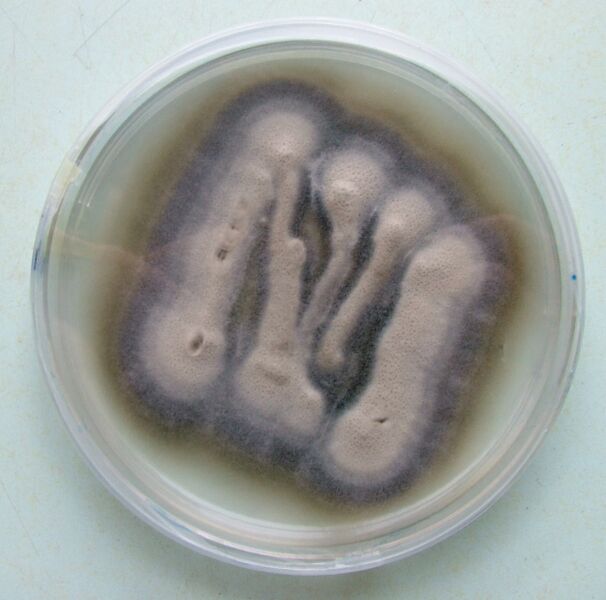
ملف:Verticillium theobromae culture.jpg
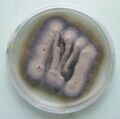
تصغير للنسخة بتاريخ 21:56، 14 أكتوبر 2023

ملف:Verticillium theobromae culture.jpg
حجم هذه المعاينة: 606 × 600 بكسل. البعد الآخر: 1٬254 × 1٬241 بكسل.
الملف الأصلي (1٬254 × 1٬241 بكسل حجم الملف: 481 كيلوبايت، نوع MIME: image/jpeg)
وصف قصير
| Description |
English: Culture of Verticillium theobromae, showing different coloured zones in the mycelium, grown on potato-dextrose-agar medium
(Dutch) |
| Date | 2007-01-29 |
| Source | Own work |
| Author | Annabel |
ترخيص
|
تاريخ الملف
اضغط على زمن/تاريخ لرؤية الملف كما بدا في هذا الزمن.
| زمن/تاريخ | صورة مصغرة | الأبعاد | مستخدم | تعليق | |
|---|---|---|---|---|---|
| حالي | ★ مراجعة معتمدة 21:56، 14 أكتوبر 2023 | | 1٬254 × 1٬241 (481 كيلوبايت) | Pastakhov (نقاش | مساهمات) | Upload https://upload.wikimedia.org/wikipedia/commons/d/d6/Verticillium_theobromae_culture.jpg |
لا يمكنك استبدال هذا الملف.
وصلات
لا يوجد صفحات تصل لهذه الصورة.